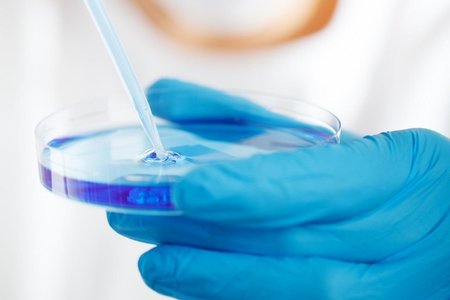
Как обычные случайности изменили ход истории

Удивительные открытия
В этом разделе собраны удивительные открытия в разных областях науки, истории, природы и технологий. Здесь вы найдёте материалы о находках, которые меняют наше представление о мире и вдохновляют на новые исследования.
Интересные открытия всегда будоражат воображение, ведь именно они позволяют человечеству двигаться вперёд. В этой подборке собраны материалы о научных достижениях, археологических находках, медицинских прорывах, открытиях в космосе и удивительных фактах из мира природы. Каждое новое открытие меняет наше восприятие окружающего мира и доказывает, что впереди ещё множество тайн и загадок.
Археология и история раскрывают тайны древних цивилизаций, а находки учёных помогают глубже понять прошлое человечества. Наука и техника ежедневно приносят открытия, которые делают нашу жизнь удобнее и безопаснее: от инновационных лекарств до умных технологий. Природа же продолжает удивлять редкими видами животных, необычными явлениями и скрытыми процессами, которые только предстоит изучить.
Интересные открытия касаются и космоса — новые данные о планетах, галактиках и вселенной расширяют границы знаний и подталкивают к новым исследованиям. Каждое такое открытие — шаг в будущее, возможность прикоснуться к неизвестному и вдохновиться величием науки.
Если вам нравятся необычные факты, научные достижения и открытия со всего мира, следите за обновлениями этой рубрики. Удивительные открытия в науке, истории, природе и технологиях помогут узнать больше и сделать ваш кругозор шире.